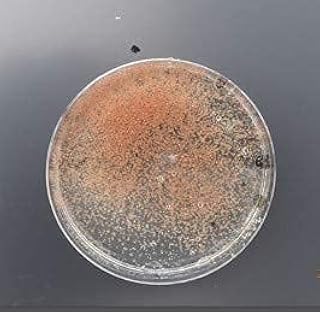

【長期保存OK】タマミジンコ 休眠卵 1000粒 (約2,000匹) + 粉末 クロレラ セット めだか 金魚 の 活餌 に 栄養満点
めだかなどの小型魚の定番の活餌「タマミジンコ」の休眠卵となります。 冷蔵で1年以上の保存ができ、餌として与えたいときに孵化させて使えるため大変便利です。 また成体で購入する場合によく別種のミジンコや微生物が混入していますが、休眠卵から飼育すれば純粋な100%のタマミジンコを育てることができますのでリセット時などにもおすすめです。 有名ブリーダー様、熱帯魚ショップ様、教育機関(中学、高校、大学の研究室)に支持され納品させていただいております。 お取引後もアフターフォローとして質問など受け付けてます。 是非お試しください。 和香(なごやか) 【商品内容】 ・タマミジンコ休眠卵 (1粒に2匹孵化します 孵化率80%) ・ミジンコ休眠卵の孵化説明書 めだかなどの小型魚の定番の活餌「タマミジンコ」の休眠卵となります。 冷蔵で1年以上の保存ができ、餌として与えたいときに孵化させて使えるため大変便利です。 また成体で購入する場合によく別種のミジンコや微生物が混入していますが、休眠卵から飼育すれば純粋な100%のタマミジンコを育てることができますのでリセット時などにもおすすめです。 有名ブリーダー様、熱帯魚ショップ様、教育機関(中学、高校、大学の研究室)に支持され納品させていただいております。 お取引後もアフターフォローとして質問など受け付けてます。 是非お試しください。 和香(なごやか) 【商品内容】 ・タマミジンコ休眠卵 (1粒に2匹孵化します 孵化率80%) ・ミジンコ休眠卵の孵化説明書
・タマミジンコ休眠卵 (1粒に2匹孵化します 孵化率80%) ・ミジンコ休眠卵の孵化説明書 ※休眠卵を冷蔵保存したものです。 乾燥卵ではございません。 冷蔵保存にて1年ほど保存可能です。 この他の数量は2000粒/3000粒/5000粒をご用意しております。 ※増殖に効果的な 粉末生クロレラ濃縮原液とのセットも各サイズご用意しております。 めだか・金魚・らんちゅう・グッピーなどの活餌に最適 和香 タマミジンコ休眠卵1000粒(2000匹)★長期保存★ らんちゅう グッピー ミジンコ みじんこ タマミジンコ めだか メダカ 稚魚 金魚 熱帯魚 観賞魚 活餌 生餌 生き餌 エサ えさ 餌 めだか餌 繁殖 増殖 飼育 アクアリウム 水槽 なごやか 和やか 商品番号 tamaegg1000k 個数 総額: ¥2,140 ポイントの合計: 22 pt 3点ともカートに入れる これらの商品は、それぞれ別の出品者から販売、発送されます。 詳細の表示 対象商品: ★タマミジンコ休眠卵★約1,000粒 2,000匹相当 ¥980 (¥980/個) 10ポイント (1%) ミジンコ・インフゾリア繁殖促進飼料 100g【ムックリワーク ※マニュアル、投与スプーン付き うたかた本舗】 ¥480 (¥5/g) 5ポイント (1%) 《めだか街道》活タマミジンコ生体0.3g(約900匹)培養繁殖説明書付きで安心! 濃縮生クロレラ30ml3本の餌つき【生クロレラ水約350mlに入れて発送】メダカの安心活餌 ¥680 (¥680/個) 7ポイント (1%) この商品を見た後に買っているのは?
NEW スピルリナEX 1000粒×2本入り

Category : Hpc
アクティブ.E 1000粒

Category : ペットフード・ペット用品
体内美人 青汁粒250g(1000粒)

Category : Hpc
ザ・スピルリナEX 1000粒×2本入り

Category : Hpc
DIC ライフテック スピルリナNEXT 1000粒

Category : Hpc
【長期保存OK】和香特選粉末生クロレラ原液 50ml 相当分 めだか金魚の針子稚魚 ミジンコ ワムシに効果期待できます

Category : ペットフード・ペット用品
美味鹿肉 犬用 エゾ鹿ジャーキー スティック(125g) 栄養満点 北海道えぞ鹿肉使用

Category : Pets
自然工房あまぷれファーム 餌用 コオロギ 生き餌 SSサイズ 栄養満点 低カロリー エサ ペット 爬虫類 両生類 ブレンドフード2g付き (50匹)

Category : ペットフード・ペット用品
チョーセイ 春ウコン粒 1000粒

Category : Hpc
ヤクケン バイオリンク 1000粒

Category : Hpc
(活餌)タマミジンコ 増量 800ml(200匹~[生体]

Category : ペットフード・ペット用品
藤めだか (生餌)タマミジンコ 種水 (460ml)

Category : ペットフード・ペット用品
【人気商品】 タマミジンコ 10,000匹

Category : ペットフード・ペット用品
マインドエース平型[1000粒]

Category : Hpc
タマミジンコ 400ml(100匹~[生体]
Category : ペットフード・ペット用品
タマミジンコ 400ml(100匹以上)+ミジンコ増殖餌2種20g

Category : ペットフード・ペット用品
栄養満点 小動物 ベビーミルク 100g

Category : ペットフード・ペット用品
【メダカの友】タマミジンコ 約1500匹(0.5g)【生クロレラ水に入れて発送】

Category : ペットフード・ペット用品
玉樹 クロレラ 1000粒

Category : Hpc
ティー・エス・アイ びわまる 徳用 1000粒×2セット

Category : Hpc









